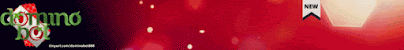

ADIK IPARKU YANG MONTOK Part 3
Aku yang mengetahuinya tertawa dalam hati sambil terus pura pura sibuk setelah beberapa saat sepertinya dia tidak berkedip akupun mengagetkannya.
“Cintia kamu melongo liat apaan” sambil kulirik selangkanganku yang aku kedut kedutkan.
“Ah.. emhhh enggak kok kak” dia nampak gugup dan mukanya memerah.
“ Tolong itu dong kunci di bawahmu”
Aku kembali pura pura sibuk sambil sesekali kulirik dia yang diam diam melihat selangkanganku terus.
“Tadi lemnya belum kering jadi lepas CASPO777 SLOT sambungannya” aku menjelaskan ke dia tapi dia seperti tidak mendengar.
“Eh kamu ngeliatin ini ya” sambil ku genggam kontolku dari luar celana.
“Iya eh enggak kok” dia berkelit dan mukanya semakin merah.
“Gak usah malu, kamu mau liat? Nih liat” aku mengeluarkan kontolku yang tegang dihadapannya.
“Ih kak Deny porno banget sih, serem tau”
“Kamu belom tau sih, ini tuh rasanya enak banget! Kalo kamu udah pernah ngerasain pasti ketagihan deh!” Aku menggoyang goyangkan kontolku sementara meskipun dia melengos tapi kadang dia melirik.
“Akukan suka nyolek tetek kamu Cintia!
Sekarang kalo kamu mau nyolek punya kakak silahkan aja, mumpung mbakmu di depan sibuk” aku menggapai tangannya untuk memegang kontolku tapi dia menolak.
“Nggak ah kak, serem, takut”
“Kalo gak mau ya udah” akupun memasukkan kontolku kedalam celana dan aku tau dia melirik..
“Ya udah kita terusin kerjaannya dulu Cintia”
dia menggangguk dan meneruskan memperhatikanku yang merapikan sambungan peralon yang tadi sudah kuberi lem. Mukanya masih merah dan sesekali dia melirik selangkanganku yang dengan sengaja terus ku kedut-kedutkan.
“Ok Cintia dah selesai” akupun membereskan CASPO777 LINK peralatanku dan dia ikut membereskan ember dan membawanya ke kamar mandi setelah dia menghidupkan mesin air untuk mengisi tower.
Cintia tidak langsung keluar kamar mandi dia menunggu air untuk mencuci tangannya yang kotor aku yang masih bernafsu menyusulnya pura pura ingin melihat airnya sudah bening apa belum.
“Cintia coba buka krannya airnya udah butek gak?” dia sedikit menungging saat itu aku dengan cepat menempelkan kontolku ke pantatnya sambil ku kedut kedutkan seolah olah ingin ikut melihat ke dalam bak air yang di bukanya.
“ Ih kak roy nempel nempelin gini sih” dia meng goyang-goyangkan pantatnya
“Nggak sengaja Cintia, tapi kok pantatmu anget banget sih”aku semakin menekan merapat ke beongkahan pantatnya
“Kak udah dong geli nih” dia ingin beranjak
“Eh ntar dulu tanggung enak banget nih”
“Ih enaknya dimana lagi” dia mencibir”
“Loh mosok kamu belum tau kalo bisa enak” aku diam diam mengeluarkan kontolku dari celana boxerku
“Dari tadi gak enak tapi kak Deny berat”
Aku mulai menjepitkan kontolku di tengah tengah selangkangannya, sambil ku gesek gesekan terus kontolku tanpa di ketahuinya kalau kontolku sudah diluar celana.
“Kalo sekarang gimana Cintia?” dia sedikit melebarkan selangkangannya dan nampak sudah mulai merasakan lain. LANJUT PART 4 YAA...


.jpg)


.jpg)


.jpg)


.jpg)


.jpg)


.jpg)


.jpg)


.jpg)
.jpg)


.jpg)


.jpg)


.jpg)

.jpg)
.jpg)
.jpg)
